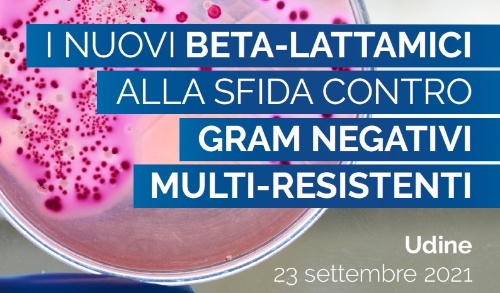
Die neuen Beta-Laktam Antibiotika zur Herausforderung gegen multiwiderstandsfähigen gramnegativen Bakterien

News

17. September 2021
Zusätzliche Verabreichung für Impfung gegen SARS Co-V-2
Ab Montag, den 20. September ab 9.00 Uhr starten die Terminvereinbarungen für die dritte Verabreichung der Impfstoffe gegen COVID-19

8. September 2021
Ausschreibung zur Vorlage von Anträgen für Annahme und Abrechnung zur Zuteilung von Betten in Heimen für pflegebedürftige Senioren
Ablauffrist 27. September

6. September 2021
Die Impfstätte im Messegelände befindet sich in einer neuen Messehalle
Das Hauptzentrum ASUFC für Immunisierungskampagne wird ab dem 13. September von der Messehalle 8 auf Messehalle 4 verlegt.

1. September 2021
I colori del crescere (Farben zum Grosswerden): Treffen fuer Eltern
Resia - September 2021

1. September 2021
Impfungen: ohne Terminvereinbarung für Personal und Universitätsstudenten in Triest und Udine
Ab 1. September für Schüler und Studenten jeden Schultyps in Friaul Julisch-Venetien.

1. September 2021
Verlängerung der Ablauffrist der Einkommensbefreiungsbescheinigungen 2019 und 2020
Die unterzeichneten Einkommensbefreiungsbescheinigungen der Jahre 2019 und 2020 werden bis 31. Dezember 2021 verlängert.
25. August 2021
Die neuen Beta-Laktam Antibiotika zur Herausforderung gegen multiwiderstandsfähigen gramnegativen Bakterien
23. September um 13.00 Uhr in Udine - Piazzale Kolbe, 3

25. August 2021
Spende der Gruppe Danieli für die Kinderklinik im Krankenhaus in Udine
Ein Ultraschallgerät der neuesten Generation für die von Frau Professorin Paola Cogo geleitete Klinik.

25. August 2021
Krankenhaus in Udine: Parkplatz P1 ist am Donnerstag, den 26. August geschlossen
Von 8.45 Uhr bis 17.00 Uhr